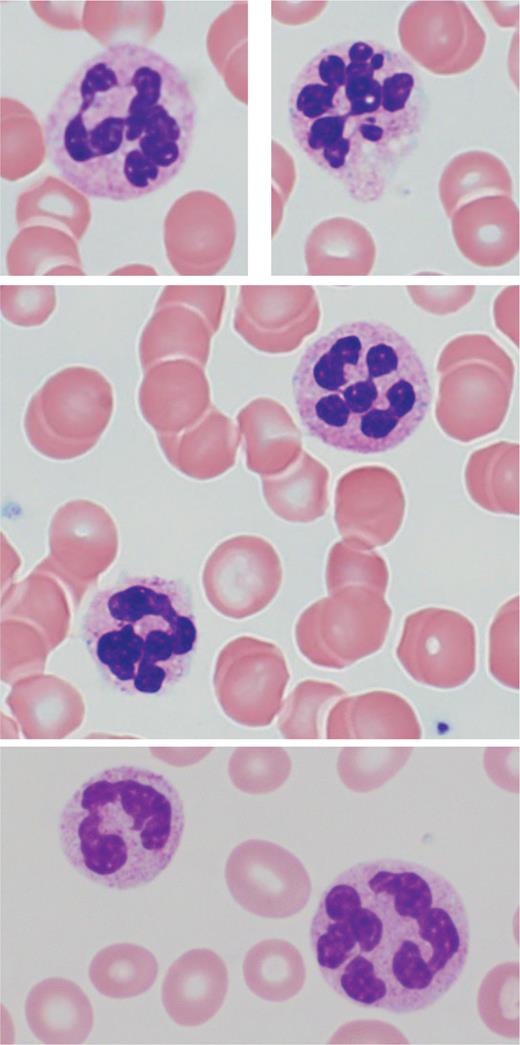
Top and middle row are from the same patient. Bottom row is from a different patient.

Pathophysiology
Vitamins B12 (cobalamin) and B9 (folate) are both coenzymes necessary for DNA synthesis, and their deficiencies are primary causes of megaloblastic anemia (Figure 1). Deficiencies in B12 and/or folate can have profound clinical consequences, with substantial morbidity and potentially long-lasting sequelae.
Simplified representation of vitamin B12-dependent enzymatic pathways
Analytes useful for evaluation for B12/folate deficiency are bolded. Diagram based on Figure 2 from article by Agata Sobczynska-Malefora, MSc, PhD, and colleagues.25 Abbreviations: HoloTC, holotranscobalamin; SAH, S-adenosyl homocysteine; SAM, S-adenosyl methionine.
Analytes useful for evaluation for B12/folate deficiency are bolded. Diagram based on Figure 2 from article by Agata Sobczynska-Malefora, MSc, PhD, and colleagues.25 Abbreviations: HoloTC, holotranscobalamin; SAH, S-adenosyl homocysteine; SAM, S-adenosyl methionine.
Causes of B12 deficiency include malabsorption (e.g., in the setting of pernicious anemia, gastrectomy, or gastric bypass, and with stomach acid-blocking drugs) and dietary deficiency (due to diet low in meat and dairy products).1 A “functional” B12 deficiency can result from prolonged nitrous oxide (N2O) use/abuse, which results in inactivation of B12 by a block in the conversion from reduced to oxidized form.2,3
Folate deficiency may be caused by decreased intake of the nutrient, impaired absorption (e.g., in small intestinal disease), or increased requirements (e.g., with pregnancy, lactation, or hemolytic anemias).4 Folate deficiency has become much less common in countries that mandate the fortification of grains and cereal with folic acid;5 however, folate levels may be low in chronic alcoholism due to multiple mechanisms beyond dietary deficiency.6
Clinical Presentation
B12 deficiency can present with a myriad of signs and symptoms,1 including weakness, palpitations, fatigue, lightheadedness, and/or shortness of breath due to anemia. Potential neurologic manifestations include paresthesia, peripheral neuropathy, and gait abnormalities (due to loss of vibratory sense and proprioception). There may also be abnormalities of the autonomic nervous system, changes to cognition, skin hyperpigmentation, or jaundice.5 In folate deficiency, the main presentation is anemia. In pregnancy, folate deficiency increases the risk of fetal neural tube defects.7
Peripheral Blood and Bone Marrow Findings
Classic peripheral blood features in megaloblastic anemia include an elevated mean corpuscular volume (MCV) of greater than 100 fL, normochromic red blood cells (RBCs) with anisopoikilocytosis, and circulating hypersegmented neutrophils (Figure 2). A hypersegmented neutrophil is defined as one with six or more nuclear lobes separated by thin nuclear strands. While a rare hypersegmented neutrophil is not specific for megaloblastic anemia, the specificity increases with the number of nuclear segments and hypersegmented cells. The MCV may be normocytic or even microcytic in the setting of concomitant iron deficiency, chronic inflammatory state, or renal disease.8 Mild leukopenia and/or mild thrombocytopenia is also not uncommon.9
Circulating hypersegmented neutrophils (Giemsa stain, 100x)
Top and middle row are from the same patient. Bottom row is from a different patient.
Top and middle row are from the same patient. Bottom row is from a different patient.
Pancytopenia is identified in 5% of patients with B12 deficiency and may be striking,10 while cytopenia in B12 or folate deficiency occasionally leads to concern for a primary marrow process and subsequent bone marrow biopsy (Figure 3). Bone marrow features in megaloblastic anemia include hypercellularity with erythroid predominance and a left-shift in erythroid maturation, with increased early erythroid precursors (pronormoblasts). The dyssynchrony between DNA synthesis and RNA/protein synthesis in megaloblastic anemia leads to nuclear-cytoplasmic asynchrony, with less mature chromatin for the degree of hemoglobinization of the cytoplasm in erythroid precursors. Nuclear budding and multinucleation of erythroid precursors may also be present. Dyssynchrony in granulocytic precursors is characterized by giantism of bands and metamyelocytes.9 Many of the bone marrow features in megaloblastic anemia overlap with those seen in myeloid neoplasm (particularly myelodysplastic syndrome/neoplasm or acute erythroid leukemia), warranting caution on the part of the interpreting pathologist and clinical provider.11-14
Images from Giemsa-stained bone marrow aspirate smears from a patient with folate deficiency and pancytopenia
The patient’s folate level at the time of biopsy was 1.4 ng/mL (reference range: 7.0-31.0 ng/mL). Peripheral blood counts normalized after folate repletion. Myeloid precursors show megaloblastic changes, including giantism of bands and metamyelocytes (A, 100X). The erythroid precursors show nuclear-cytoplasmic asynchrony, as well as nuclear budding and late mitoses (A, B, 100X; C, 50X). The megakaryocytes also show nuclear abnormalities (D, 50X). The marrow hypercellularity is seen on hematoxylin-and-eosin-stained section of the core biopsy (E, 20X). Lacking from this case is the marked erythroid predominance and erythroid left-shift that can be seen in some cases of vitamin B12 or folate deficiency.
The patient’s folate level at the time of biopsy was 1.4 ng/mL (reference range: 7.0-31.0 ng/mL). Peripheral blood counts normalized after folate repletion. Myeloid precursors show megaloblastic changes, including giantism of bands and metamyelocytes (A, 100X). The erythroid precursors show nuclear-cytoplasmic asynchrony, as well as nuclear budding and late mitoses (A, B, 100X; C, 50X). The megakaryocytes also show nuclear abnormalities (D, 50X). The marrow hypercellularity is seen on hematoxylin-and-eosin-stained section of the core biopsy (E, 20X). Lacking from this case is the marked erythroid predominance and erythroid left-shift that can be seen in some cases of vitamin B12 or folate deficiency.
Evaluation for B12 or folate deficiency is important in the workup of a patient with anemia or pancytopenia, and genetic evaluation often contributes valuable information providing support either for or against myeloid neoplasm. Of note, identification of a nutritional deficiency does not exclude a concurrent myeloid neoplasm, and morphologic clues such as Auer rods may give a hint to the underlying pathology.
Diagnosis/Laboratory Evaluation
Assays for B12 and folate are commonplace in the clinical laboratory, and recognition of the clinical symptoms of B12 and folate deficiency is an important first step in diagnosis.15 Direct assays using automated immunoassays have largely replaced older microbiological-based methods.16 Erythrocyte (RBC) and whole blood folate assays better evaluate long-term stores of folate, while serum folate is more representative of recent intake. Serum folate has become the preferred assay due to decreased test complexity and variability.17,18 Serum B12 is generally used as the first-line test for B12 evaluation. While newer, “active” B12 assays such as holotranscobalamin (HoloTC), which measure bound-B12 levels after uptake, are also available, they have not seen widespread adoption.19,20 In contrast to B12, HoloTC concentrations have been seen to remain relatively constant throughout pregnancy in B12-replete individuals, leading researchers to investigate its utility as a predictive marker for B12 deficiency in this population.21,22
In addition to direct B12/folate measurement assays, other assays can help identify and characterize deficiency. These include measurement of downstream (indirect/functional) markers that correlate to a folate/B12 deficiency, or the identification of autoantibodies that can cause deficiency. Indirect/functional assays for B12 deficiency are urine/serum methylmalonic acid (MMA) and serum homocysteine (HCY), both of which increase with B12 deficiency. HCY is measured by immunoassay, while MMA is measured by mass spectrometry.23 Folate deficiency leads to an increase in HCY as well, as the conversion step of HCY to methionine requires both folate and B12. In contrast, the increase in MMA seen in B12 deficiency comes from a folate-independent pathway; therefore, MMA levels will be normal in isolated folate deficiency. One limitation is that both HCY and MMA can increase in renal disease.24 In cases of N2O abuse, highly elevated HCY is seen first, followed by a slow decrease in total and active B12, as well as slight elevations in MMA.25
B12 absorption requires intrinsic factor (IF), released by parietal cells in the stomach, for transport to the distal ileum. Pernicious anemia is an autoimmune disease where chronic gastritis results from autoantibodies to parietal cells (anti-parietal cell antibody [APCA]) or IF (intrinsic factor blocking antibody [IFBA]). Because immunoassays for B12 use IF in their design, autoantibodies to IF can potentially cause an interference in the assay that can lead to a falsely elevated result, potentially masking a true deficiency.26 This is one reason why B12 results alone may not be sufficient to rule out deficiency. Immunoassays are available for both IFBA and APCA, and APCA can also be visualized by immunofluorescence assay. B12 deficiency related to pernicious anemia can also result in elevated serum gastrin levels, as destruction of parietal cells leads to an increase in stomach pH, which in turn causes gastrin secretion.27 Therefore, serum gastrin levels can be another marker to evaluate for pernicious anemia.
Conclusions
Early recognition of the clinical symptoms of B12 deficiency is critical to preventing potentially irreversible sequelae. Use of an appropriate diagnostic testing algorithm, potentially including measurement of serum B12, serum active B12, urine/serum MMA, and serum HCY, could help prevent diagnostic confusion, particularly in select clinical scenarios such as N2O abuse or pregnancy. Additionally, because B12 or folate deficiency may present with striking pancytopenia, with bone marrow biopsy results overlapping with those of myeloid neoplasm, caution is warranted on the part of the interpreting pathologist and clinical provider.
Competing Interests
Drs. Courville and Larkey indicated no relevant conflicts of interest.